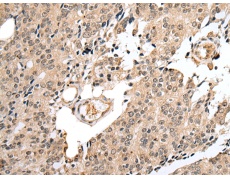
一抗

中文名稱: 兔抗GTF2H2多克隆抗體
英文名稱: Anti-GTF2H2 rabbit polyclonal antibody
別 名: p44; BTF2; TFIIH; BTF2P44; T-BTF2P44
抗 原:GTF2H2
相關(guān)類別: 一抗
儲 存: 冷凍(-20℃)
宿 主: Rabbit
反應種屬: Human, Mouse, Rat
標 記 物: Unconjugate
克隆類型: rabbit polyclonal
技術(shù)規(guī)格
|
Background: |
This gene is part of a 500 kb inverted duplication on chromosome 5q13. This duplicated region contains at least four genes and repetitive elements which make it prone to rearrangements and deletions. The repetitiveness and complexity of the sequence have also caused difficulty in determining the organization of this genomic region. This gene is within the telomeric copy of the duplication. Deletion of this gene sometimes accompanies deletion of the neighboring SMN1 gene in spinal muscular atrophy (SMA) patients but it is unclear if deletion of this gene contributes to the SMA phenotype. This gene encodes the 44 kDa subunit of RNA polymerase II transcription initiation factor IIH which is involved in basal transcription and nucleotide excision repair. Transcript variants for this gene have been described, but their full length nature has not been determined. A second copy of this gene within the centromeric copy of the duplication has been described in the literature. It is reported to be different by either two or four base pairs; however, no sequence data is currently available for the centromeric copy of the gene. |
|
Applications: |
ELISA, IHC |
|
Name of antibody: |
GTF2H2 |
|
Immunogen: |
Fusion protein of human GTF2H2 |
|
Full name: |
general transcription factor IIH, polypeptide 2, 44kDa |
|
Synonyms: |
p44; BTF2; TFIIH; BTF2P44; T-BTF2P44 |
|
SwissProt: |
Q13888 |
|
ELISA Recommended dilution: |
5000-10000 |
|
IHC positive control: |
Human prostate cancer and Human brain |
|
IHC Recommend dilution: |
25-100 |

 購物車
購物車 幫助
幫助
 021-54845833/15800441009
021-54845833/15800441009